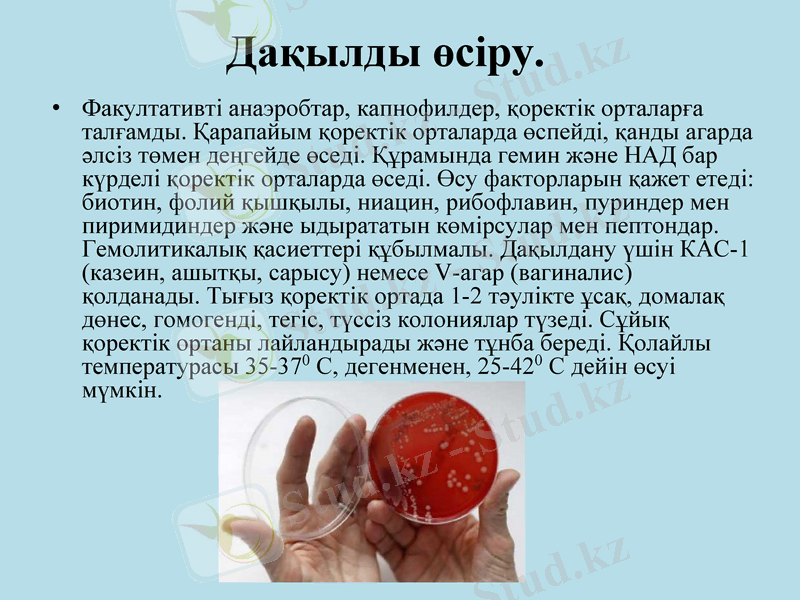
Slide 4

Гарднереллалар: экологиясы, адамға патогенділігі және ағзадағы орналасуы



СӨЖ Тақырып:Гарднереллалар. Экологиясы. Адамға потогенділігі және аурудың ағзасындағы орналасуы
Топ:212Б
Дайындаған: Қалман Салтанат
Тексерген:Нурсейтова Т. Х
Батыс Қазақстан мемлекеттік медицина университеті

Гарднереллалар вагиноз ауруының қоздырғышы, Гарднереллез-Gardnerella vaginalis тудыратын антропонозды оппортунистік инфекция, басқа облигатты анаэробтармен ассоциация түрінде қынаптың қабынуына әкеледі, нәтижесінде бұл ағзада жағымсыз иіс («балық» иісіне ұқсас), су тәрізді гомогенді көп мөлшерде бөлінді пайда болады. Туыстастығы:Gardnerella
Түрі:. Gardnerella vaginalis
Бұдан бұрын микроб Haemophilus туыстастығына кіретін. Дегенменен, қанның X- және V- өсу факторларына тәуелді болмағандықтан жеке түрге бөлінген.
Гарднереллалар

Морфологиясы
. Ұсақ таяқшалар немесе коккобациллалар, жиі шоғырланған, орналасады. Нейссер әдісімен анықталатын метахромазиялық дәндер көрінеді. Жағындыда жұптасып, V, Y- тәрізді немесе қатарласып орналасады, сондықтан коринебактерияларға ұқсас келеді. Грам әдісімен бояғанда құбылмалы болып келеді, 8-12 сағаттық дақылы-грам теріс, қолайлы қорекік ортада өскендері грам оң болып бойялады. Жасуша қабырғасы грам оң бактериялардың құрылымына ұқсас: оның құрамында треонин, триптофан, лизин, глютамин және аспрагин қышқылдары орналасқан. Дегенмен, арабиноза (коринебактерияларға тән), тейхой диаминпимелин қышқылы жоқ. Грам теріс бактерияларға тән майлы қышқылдар анықталмайды. Капсуласы, талшықтары жоқ, спора түзбейді. (38-сурет) .
Дақылды өсіру.
Факултативті анаэробтар, капнофилдер, қоректік орталарға талғамды. Қарапайым қоректік орталарда өспейді, қанды агарда әлсіз төмен деңгейде өседі. Құрамында гемин және НАД бар күрделі қоректік орталарда өседі. Өсу факторларын қажет етеді: биотин, фолий қышқылы, ниацин, рибофлавин, пуриндер мен пиримидиндер және ыдырататын көмірсулар мен пептондар. Гемолитикалық қасиеттері құбылмалы. Дақылдану үшін КАС-1 (казеин, ашытқы, сарысу) немесе V-агар (вагиналис) қолданады. Тығыз қоректік ортада 1-2 тәулікте ұсақ, домалақ дөнес, гомогенді, тегіс, түссіз колониялар түзеді. Сұйық қоректік ортаны лайландырады және тұнба береді. Қолайлы температурасы 35-370 С, дегенменен, 25-420 С дейін өсуі мүмкін.

Ферменттік белсенділігі.
Хемоорганотрофтар.
Метаболизмі ашыту типіне жатады, нәтижесінде сірке қышқылы пайда болады. Ферменттік белсенділігі төмен:
каталаза және оксидазаны түзбейді. Крахмал, мальтозаны ыдыратады.

Антигендік құрылымы.
Преципитация А реакциясымен гарднереллалардың 7 серологиялық топтарын бөлуге болады. Гликопептидті жалпы антигенін агглютинациялық реакцияның, ИФТ көмегімен анықтайды. Иммунды флюоресценция реакциясында Candida albicans-пен жалпы антигені анықталды.

Патогенділік факторлары.
Гарднереллалардың кейбір штамдары қынаптың кілегейлі қабығындағы гликопептидті ыдырататын нейраминидаза түзеді.

Резистенттілігі.
.
Қоршаған ортадағы тұрақтылығы төмен. Метронидазол, триметоприм және кеңінен қолданатын антисептиктер мен дезинфектанттарға гарднереллалар сезімтал.

Эпидемиологиясы.
Инфекцияның көзі ауру адам. Таралу механизмі қарым-қатынастық, таралу жолдары - жыныстық. Гарднереллаларға адамның сезімталдығы басқа шартты-патогенді микроорганизмдерге ұқсас. Гарднереллез барлық жерде таралған, көбінесе туатын жастағы әйелдер ауырады.

Патогенезі.
Мекендейтін экологиялық орыны - қынап. Көбінесе қынаптың микробиоценоздық бұзылысына байланысты гарднереллалар әйелдердегі вагинит тудырады. Себепкер фаткорлары болатын қантты диабет, жүктілік, ұрықтандыруға қарсы гормонды препараттар, менструациялық ұзілістер, эндокриндік бұзылыстар. Осылардвң әсерінен қынаптың кілегейлі қабатында рН көрсеткіші және де қанттын мөлшері өзгереді. Нәтижесінде гарднереллалар басқа анаэробтармен бірге ассоциацияда (бактероидтар, пептострептококтар, мобилункустар) вагинит тудырады. Осы микроорганизмдер өз алдына вагинит үрдісіне әкелмейді. Соған байланысты мұндай вагиниттер бейспецификалық деп аталады.

Клиникалық көріністері
. Әйел адамдарда-вагинит, ер адамдарда - балонит, бейспецификалық уретрит және жыныс мүшелердің қабыну процестері пайда болады. Бактериялық вагинит асқынған вагинитке әкелуі мүмкін: уақытынан бұрын бала туу, жас нәрестелердің салмағы төмен болуы, уақытынан бұрын қапшықтардың жарылуы, кіші жамбас мүшелерінің қабыну аурулары және де жатырдың патологиялық қансырауы. Бактериялық вагинит 30% құрайды.

Иммунитеті.
Ауырғаннан кейін жеткілікті деңгейде қалыптаспайды. Вагиниттің қайталануы иммундық статустың бұзылуымен, соның ішінде қынаптың дисбиозы және колонизациялану бұзылуымен байланысты.

Микробиологиялық диагноз қою.
Зерттеу материалы-қынап және жатыр мойынынан алынған бөлінділер. Қолданатын зерттеу әдістері - бактериоскопиялық, бактриологиялық. Көбінесе бактериоскопиялық әдіспен диагноз қоюға болады, себебі жатырдың эпителий жасушаларында грам әдісінде құбылмалы бактериялар көп мөлшерде мекендегенде диагноз қойылады. Сонымен қатар, қосымша жанама биохимиялық зерттеулер жүргізіледі. Бактериологиялық зерттеу сирек қолданылады.

Емдеуі.
Метронидазол қолданған жағдайларда қынаптың лактобациллалары жойылады. Ал ол дисбиоздың асқынуына әкеледі. Сондықтан, метронидазолмен қатар, вагиналды эубиотиктер қолданады.
Алдын алуы. Арнайы сақтандыруы жоқ.

Әдебиеттер тізімі.
Микробиология және вирусология (жалпы бөлімі) : Оқу құралы /Ү. Т. Арықпаева, К. Х. Алмағамбетов, Н. М. Бисенова, Н. Б. Рахметова, Г. Д. Асемова, Койшебаева К. Б., Бисимбаева С. К., Калина Н. В. Астана, 2005ж
«Микроорганизмдердің морфологиясы» оқу құралы, Астана, 2004, 32б. Микробиология және вирусология (жеке бөлімі) : Оқу құралы /Ү. Т. Арықпаева, К. Х. Алмағамбетов, Н. М. Бисенова, Ә. Ө. Байдүйсенова, Н. Б. Рахметова, Г. Д. Асемова Астана, 2006ж
Воробьев А. А. "Микробиология, иммунология" М. : МИА, 2002
Аравийский Р. А., Горшкова Г. И. . Практикум по медицинской микологии.
- Іс жүргізу
- Автоматтандыру, Техника
- Алғашқы әскери дайындық
- Астрономия
- Ауыл шаруашылығы
- Банк ісі
- Бизнесті бағалау
- Биология
- Бухгалтерлік іс
- Валеология
- Ветеринария
- География
- Геология, Геофизика, Геодезия
- Дін
- Ет, сүт, шарап өнімдері
- Жалпы тарих
- Жер кадастрі, Жылжымайтын мүлік
- Журналистика
- Информатика
- Кеден ісі
- Маркетинг
- Математика, Геометрия
- Медицина
- Мемлекеттік басқару
- Менеджмент
- Мұнай, Газ
- Мұрағат ісі
- Мәдениеттану
- ОБЖ (Основы безопасности жизнедеятельности)
- Педагогика
- Полиграфия
- Психология
- Салық
- Саясаттану
- Сақтандыру
- Сертификаттау, стандарттау
- Социология, Демография
- Спорт
- Статистика
- Тілтану, Филология
- Тарихи тұлғалар
- Тау-кен ісі
- Транспорт
- Туризм
- Физика
- Философия
- Халықаралық қатынастар
- Химия
- Экология, Қоршаған ортаны қорғау
- Экономика
- Экономикалық география
- Электротехника
- Қазақстан тарихы
- Қаржы
- Құрылыс
- Құқық, Криминалистика
- Әдебиет
- Өнер, музыка
- Өнеркәсіп, Өндіріс
Қазақ тілінде жазылған рефераттар, курстық жұмыстар, дипломдық жұмыстар бойынша біздің қор #1 болып табылады.



Ақпарат
Қосымша
Email: info@stud.kz